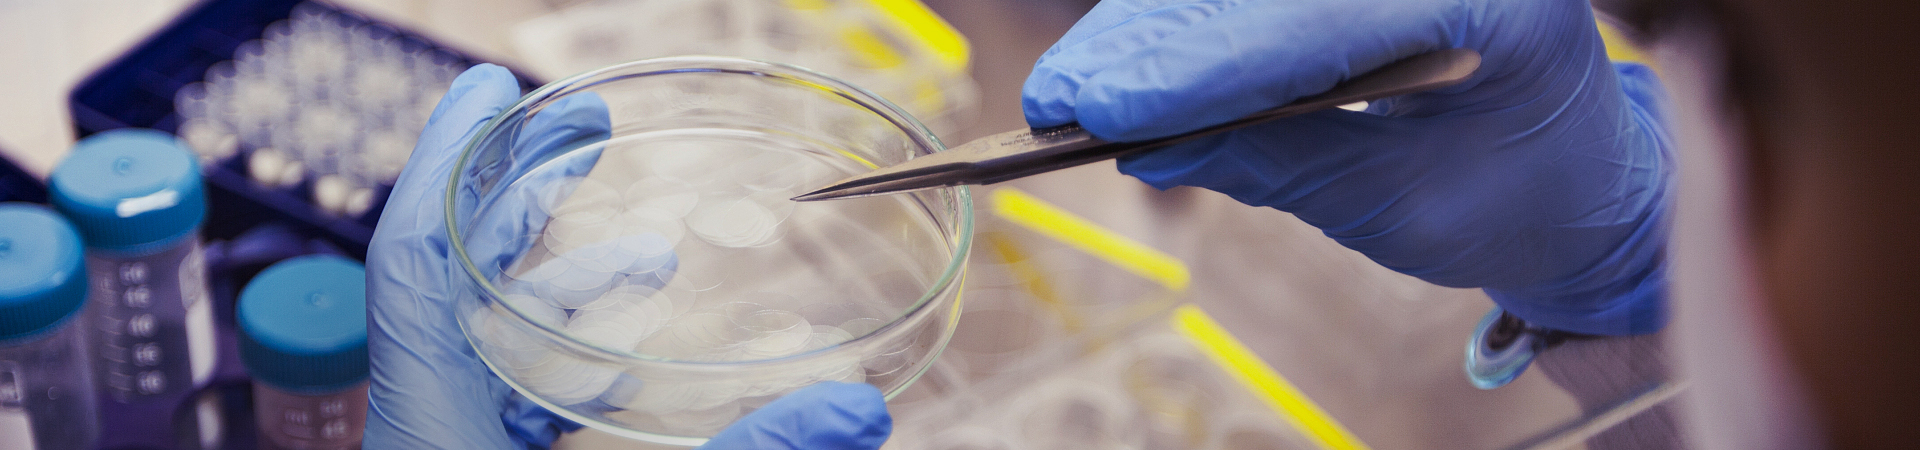

業達孵化
Yetda Incubation
煙臺業達國際生物醫藥創新孵化中心有限公司(以下簡稱“業達孵化中心”)成立于2017年5月,由煙臺經濟技術開發區管理委員會(開發區管委)和煙臺榮昌制藥股份有限公司(榮昌制藥)出資建立。業達孵化中心打造國際一流生物醫藥專業孵化器,鏈接頂級智庫和產業優勢資源,提供全流程專業化服務,助推初創企業實現創新創業夢想。

Yetda Incubation
煙臺業達國際生物醫藥創新孵化中心有限公司(以下簡稱“業達孵化中心”)成立于2017年5月,由煙臺經濟技術開發區管理委員會(開發區管委)和煙臺榮昌制藥股份有限公司(榮昌制藥)出資建立。業達孵化中心打造國際一流生物醫藥專業孵化器,鏈接頂級智庫和產業優勢資源,提供全流程專業化服務,助推初創企業實現創新創業夢想。